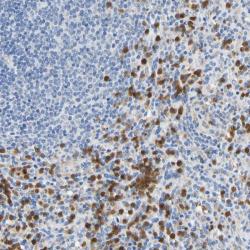

Antibody data
- Antibody Data
- Antigen structure
- References [0]
- Comments [0]
- Validations
- Western blot [1]
- Immunohistochemistry [1]
Submit
Validation data
Reference
Comment
Report error
- Product number
- sc-48388 - Provider product page

- Provider
- Santa Cruz Biotechnology
- Proper citation
- Santa Cruz Biotechnology Cat#sc-48388, RRID:AB_627989
- Product name
- Anti-NCF4
- Antibody type
- Monoclonal
- Antigen
- Recombinant full-length protein
- Reactivity
- Human
- Host
- Mouse
No comments: Submit comment
Supportive validation
- Submitted by
- per
- Main image

- Experimental details
- Western blot analysis of antibody specificity using a routine panel composed of IgG/HSA-depleted human plasma and protein lysates from selected human tissues and cell lines.
- Validation comment
- Single band corresponding to the predicted size in kDa (+/-20%).
- Primary Ab dilution
- 1:500
- Secondary Ab dilution
- 1:7000
- Lane 1
- Marker [kDa]: 219, 111, 83, 48, 32, 26, 17
- Lane 2
- RT-4
- Lane 3
- U-251MG sp
- Lane 4
- Human Plasma
- Lane 5
- Liver
- Lane 6
- Tonsil
- Theoretical target weight
- [kDa] 39
Supportive validation
- Submitted by
- per
- Main image
- Experimental details
- Immunohistochemical staining of human spleen shows strong cytoplasmic positivity in a subset of cells in red pulp.
- Validation comment
- Staining pattern consistent with experimental and/or bioinformatic data.